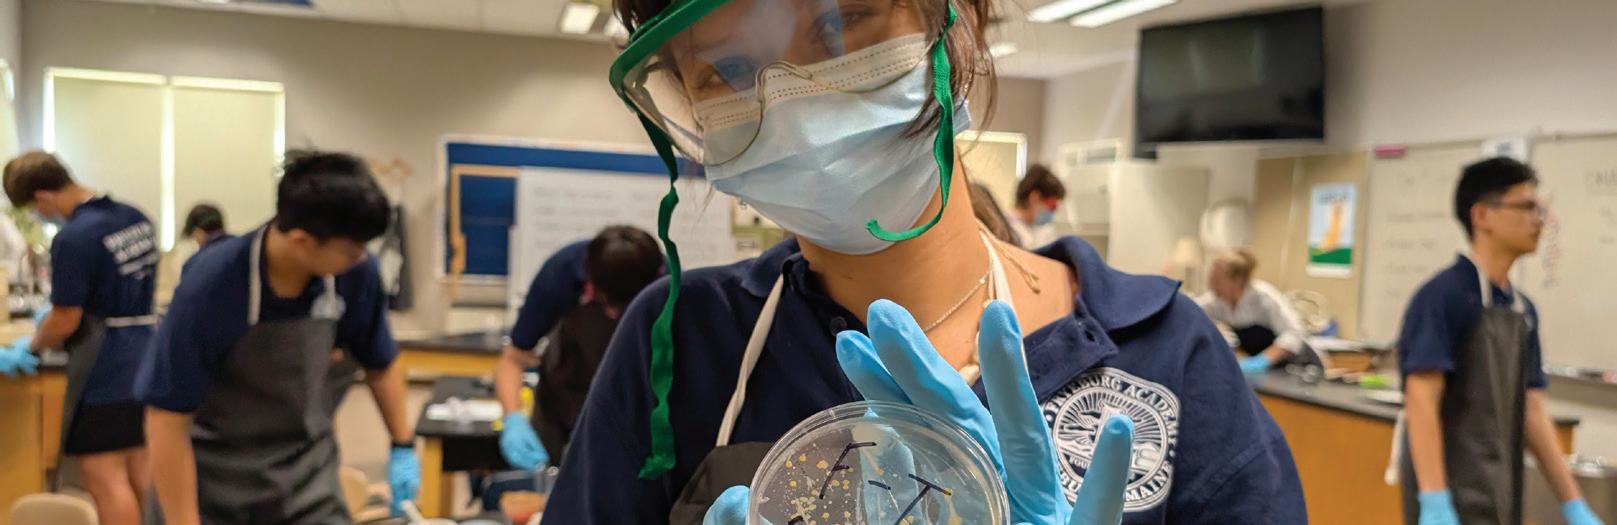

A SUMMER PROGRAM FOR STUDENTS AGES 13-17. JULY 7 - 25, 2026 | Maine, USA





![]()

A SUMMER PROGRAM FOR STUDENTS AGES 13-17. JULY 7 - 25, 2026 | Maine, USA






Join us at Fryeburg Academy Summer Term 2026, where learning meets exploration and fun. Our unique program blends the academic excellence of a New England boarding school with the unforgettable adventures of a classic Maine summer camp. With the guidance of experienced and caring educators, participants from around the globe immerse themselves in a diverse mix of morning classes, engaging afternoon activities, exciting outdoor adventures, and trips to iconic destinations such as Boston, Mount Washington, and Portland. In a warm and inclusive environment, students discover their passions, form new friendships, and create lifelong memories.
As part of a weekend trip to the beautiful and historic city of Boston, Summer Term students tour MIT and Harvard University campuses.

Fryeburg Academy’s Summer Term offers a diverse, intensive and engaging academic experience. Students take two courses during the first half of the program, followed by two different courses in the second half.
• Art
• Theater
• Business • Ceramics
• Fitness • Intro to Sociology
• Photography • Journalism
• Sports Medicine
• Food Science
• STEM Ecology
• Boarding School 101
• Social Media
• Academic English/ESL
• Lab Science
Please note that course offerings are subject to change. The final list of courses for 2026 will be shared with Summer Term students in late spring.
Summer Term courses offer various academic and extracurricular opportunities to explore students’ interests.

A TYPICAL FA SUMMER TERM DAY
7:30 AM Wake up + get ready for the day
8:00 - 8:45 AM Breakfast
9:00 - 10:30 AM Course A
10:45 - 12:30 PM Course B
12:30 - 1:15 PM Lunch
1:30 - 5:00 PM Afternoon Activity
5:00 - 6:00 PM Dinner + Free Time
7:00 PM Evening Activity
9:00 PM Dorm hangout time + relax
10:30 PM Quiet hours + lights out
WEEKEND
8:00 AM Wake up + Breakfast
9:00 AM - 8:00 PM Off-campus trip: Boston, Harvard, & MIT
10:00 PM Return to FA campus
11:00 PM Lights out- get lots of sleep for another busy day!


Students get a front row seat to observe MIT’s scientific research labs in action.

It’s the best of both worlds! We offer a wide range of trips and experiences that make the most of our natural landscape and nearby metropolises. So, whether your passion is visiting historic landmarks in Boston or paddling down the Saco River, we’ve got you covered!
• Hiking
• Swimming
• Dorm Olympics
• Canoeing
• Outlet Shopping
• Challenge Course
• College Planning
• First Aid Training
• Scenic Chairlift Ride
• Team Competitions
• Capture the Flag
• Fitness Center
• Bonfire & S’mores
• Movie Night
• Bowling
• Musical
• USA Party
• Ice Cream Social
• Outdoor Concert
• Sunset Hike
• Soccer Under the Lights
• Talent Show
• Board Games
• Karaoke Party
• Boston, Harvard & MIT
• Portland & Ferry Cruise
• Beach
• Movies
• Shopping
• Mount Washington
• and more...


Our skillful chefs and kitchen staff offer diverse meal options that include students’ national foods from many different countries.

Fryeburg Academy’s campus houses historic and state-of-the-art buildings like the LaCasce Dining Room. With its 342-seating capacity, the facility offers an expansive menu and dining space, including a large, self-serve salad bar, sandwich station, brick-oven pizza station, and various homemade desserts. Other notable facilities include the Leura Hill Eastman Performing Arts Center, home to a variety of professional and student performances and art galleries; the John L. Atwood Stadium, which offers a modern, synthetic turf field and exterior lighting for night competitions; and the popular T. Scott Gamwell Student Union, which houses a fireplace, game tables, stage, and student kitchen.

more about FA Summer Term.

July 7 - July 25, 2026 $3,900
Arrival on Tuesday, July 7
Departure on Sunday, July 25
Boarding pricing includes: airport pick-up and drop-off service, trips, activities, dormitory accommodation and meals.
Not included: health insurance, flights, personal spending money, visa fees, or unaccompanied minor fee (charged by some airlines).
Available for travel from/to Boston Logan (BOS) or Portland International Jetport (PWM) on the opening and closing days.
Health insurance is not included in the program fee. All participants are required to provide proof of insurance or purchase coverage through the school before arriving on campus.
CONTACT US summer@fryeburgacademy.org
Learn more: www.fryeburgacademy.org/summer


Maine is home to 3,500 miles of indescribably beautiful coastline, with bays, coves, and beaches.
Learn more about Fryeburg Academy Summer Term, visit www.fryeburgacademy.org/summer
Questions? Get in touch by email: summer@fryeburgacademy.org
745 Main St. Fryeburg, ME, USA 04037 | p. (+1) 207-935-2013 | www.fryeburgacademy.org